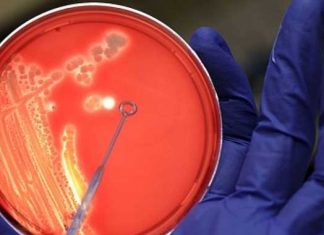
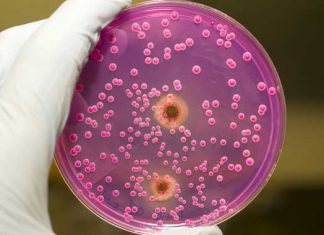

Cómo las frutas y el alcohol impactan en el cáncer de...
Las adolescentes que consumen frutas habitualmente pueden obtener beneficios de protección contra el cáncer de mama, pero el consumo de alcohol en un futuro...
Cáncer Endometrial: estudio duplica pistas sobre el riesgo genético
Un gran estudio internacional ha identificado cinco nuevas regiones genéticas - con lo que son nueve, el total de las regiones ahora conocidas - que...
Drogas para el ardor de estómago pueden envejecer vasos sanguíneos
No hay nada más molesto que, después de haber tomado aquella comida copiosa quizás acompañada con una buena cantidad de vino, sentir la sensación...
Yoga y meditación pueden reducir el riesgo de demencia
Completando un curso de yoga y meditación de 3 meses, se puede reducir el riesgo del deterioro cognitivo leve de los adultos mayores -...
Bacterias de la piel estables, a pesar de cuidado irregular
Nuestra piel es el hogar de un gran número de bacterias, hongos y virus, y cada uno de nosotros tiene una huella digital única...
Terapia con anticuerpos del VIH parece prometedora
Un nuevo estudio de los efectos de un nuevo tratamiento a base de anticuerpos sugiere que puede ofrecer una solución a largo plazo para...
Alzheimer: se necesita una red más amplia para encontrar una cura
A pesar de las 35 millones de personas en todo el mundo que sufren la enfermedad de Alzheimer, no ha habido ningún nuevo fármaco...
Esquizofrenia y trastorno bipolar ligadas a infección por levaduras
Una infección actual o anterior por Candida albicans - foto de portada - parece ser más común en algunas personas con enfermedad mental que...
Consumo de alcohol y felicidad: cuál es la realidad?
Según William Shakespeare: "El alcohol provoca el deseo pero frustra la ejecución", u otro refrán ingles que dice: Comer, beber y ser feliz!
Refranes a parte, dice...
Trastorno de estrés postraumático se podría prevenir con germenes intestinales
Debido a la naturaleza de algunas profesiones - salud (médicos, enfermeros), seguridad (ejercito, bomberos, policías), minería, etc. - estos individuos están sometidos a una...
¿Cuáles son los beneficios de las nueces para la salud?
Será difícil encontrar a quienes no les gusten las nueces, este bien conocido fruto seco típico de las navidades y fruto del árbol Nogal. Los nogales...
Bipolar, Autismo y Esquizofrenia podrían compartir origen genético
Un nuevo estudio genético en profundidad, publicado en Archives of General Psychiatry, encuentra un posible vínculo entre el trastorno bipolar, la esquizofrenia y el...